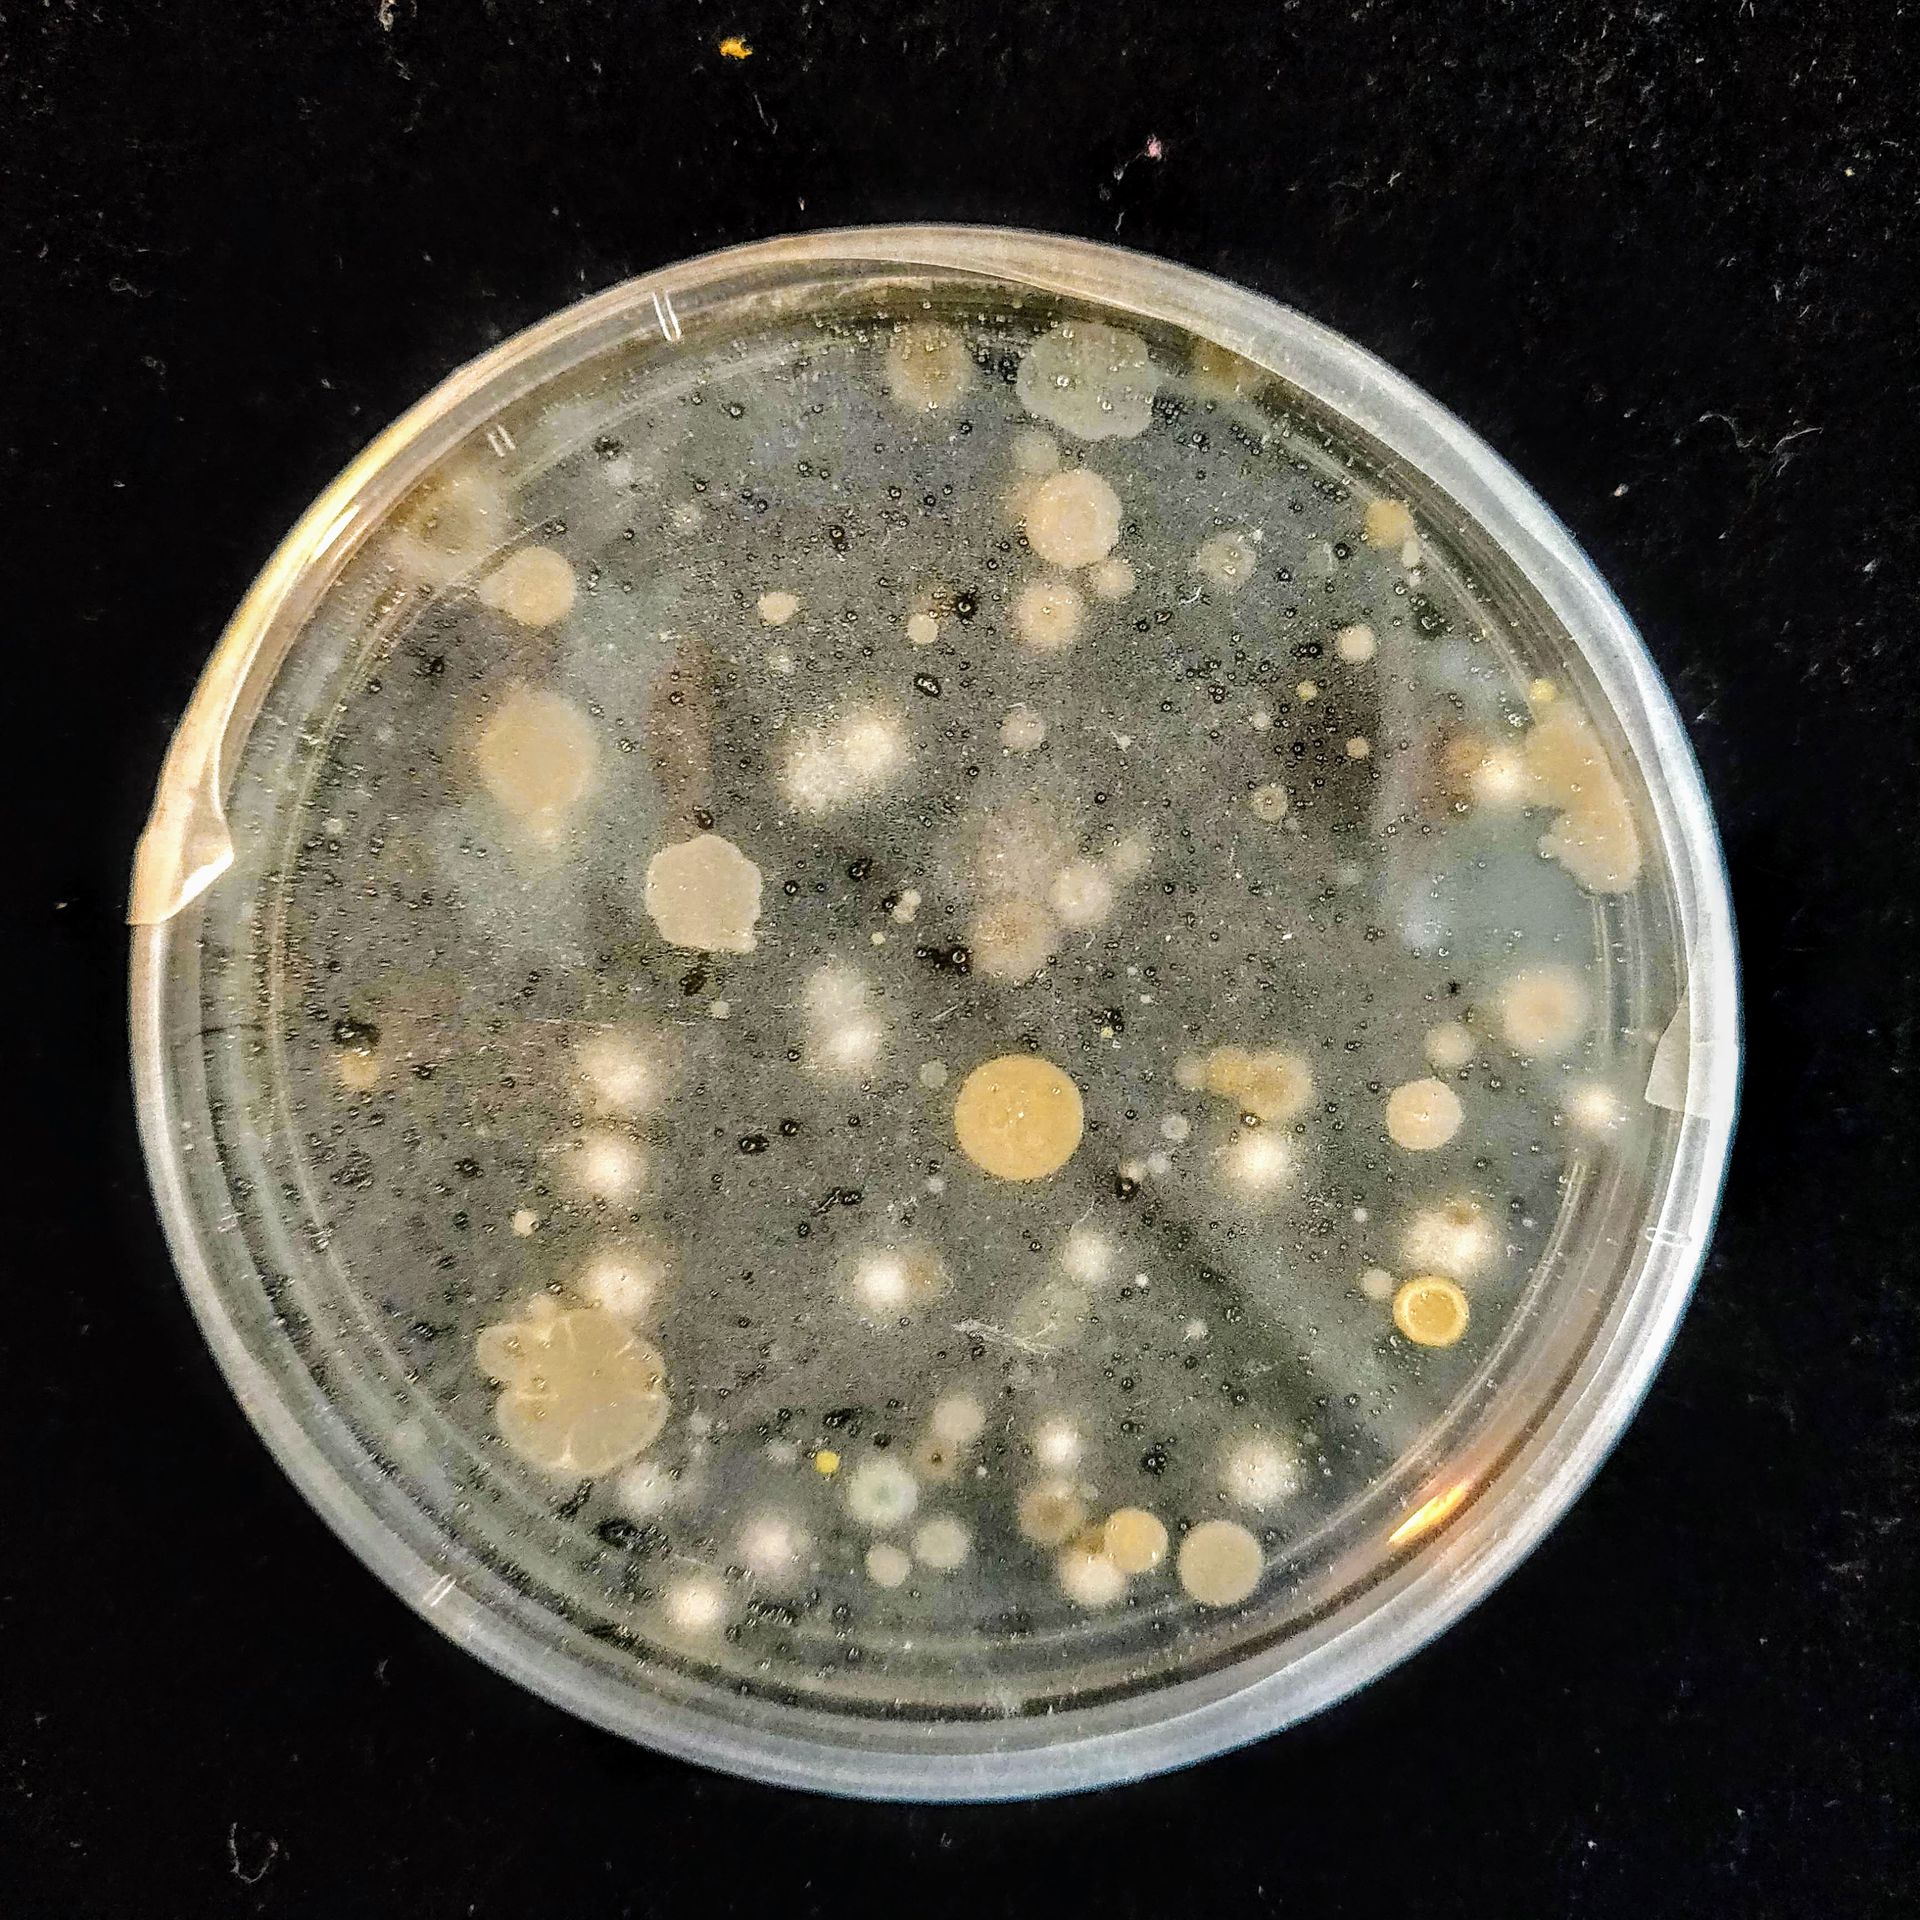

Art & Creative Practice
Decarbonising Heritage
Tom Jefferies et al., Queen’s University Belfast, Northern Ireland
Sherif Goubran et al., The American University in Cairo, Egypt
Laura Coucill et al., University of Salford, England
Time Space Existence 2023 - Venice Architectural Biennale
Venice, Italy
May - November 2023
This project responds to the global challenges of climate change, decarbonisation, and heritage protection.
Funded by the British Council, Queen’s University Belfast, American University in Cairo and University of Salford examine the (future) heritage rich contexts of Northern Ireland, Egypt and England.
Design questions are explored through experimental and digitally infused forms of co-production, to generate shared understanding of local responses to global challenges. This ‘Distributed Design Studio’ engages architectural design thinking across digital platforms to critically re-evaluate decarbonisation strategies across a range of scales, cultures, and climates.
Proposals were presented at COP27, Sharm-el-Sheikh, Egypt in November 2022.
Funded by a British Council Going Global Partnership grant.
Credit and thanks to Rebecca-Jane McConnell for editing and curating exhibition panels.

The jars can say it all
Narratives from preservation
Seasons Jars (Monica Dantas, Sherif Goubran, Nadra Wagdy)
4TH SPACE - Concordia University
Montreal - QC, CA
November 2018
An experimental object installation project for food preservation knowledge mobilization
Seasons, Stories, People.
Processes, Sciences, Tools.
Outcomes, Evolution, Futures.
Colors, Flavors, Scents.
Benefits, Dangers, Choices.
For the past two years, Season Jars have been exploring these elements - through research, practice and community. Elements that make up the constellation of food preservation.
Easy to describe in words, they are much harder to explore with just the eyes.
We will attempt to build stories of preservation in jars to be explored and deciphered by viewers at the 4th place. In this exhibition, Season Jars will embark on their first research creation project to find new ways to mobilize food preservation knowledge in the community.
Several recipes - 4 to 6 - along with the stories will be displayed in a total of about 60 mason jars of different sizes. The content of the jars will vary from food ingredients, to completed recipes, printed media, illustrative objects as well as preservation tools. The main guiding logic of the exhibition will be the seasons and the complex layering of culture, history, science and process that make up the preserved recipes displayed. The exhibition will be augmented using lighting and sounds. Printed description will also be provided. Season Jars would be interested to use the cubical exhibition equipment available at the space to organize the project.
Conjecture
Sherif Goubran
Canada 67 Pavillion
Montreal - QC, CA
October 2018
In September 2018, we transferred our project to the site of Expo-67 and occupied the Canada Pavilion. We started researching, exploring and using the space under the assumption that it is vacant. We put a lot of thinking and work in how to bring the building back to life – or in some cases, how to bring life back to the building.
Many questions related to the possible occupancy and occupants were raised by the team, the park management and the city.
Who should occupy the Canada Pavilion?
How can the space be adapted to these possible occupancies?
Collected from spaces that we used and explored in the last months, the dishes contain samples of life – the invisible kind of life. The dishes present a chance to interact, at least indirectly, with the current occupants of the Canada Pavilion.
The types of life that we see in the dishes, which were never asked to occupy the space in the first place, invite us to rethink the questions we ask about occupancy.
What types of life does this building allow for?